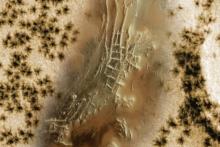
مریخ

آژانس فضایی اروپا: مریخ عنکبوت ندارد
به گزارش سیتنا، «آژانس فضایی اروپا» سطوح عنکبوتی شکل در مریخ را فورانهای گاز کربن دیاکسید در منطقهای از این سیاره معرفی کرد. این ساختارها به لطف «مدارگرد مارس اکسپرس»(Mars Express orbiter) و «مدارگرد ردیاب گاز اگزومارس»(ExoMars Trace Gas Orbiter) متعلق به «آژانس فضایی اروپا» که در منطقه قطب جنوب مریخ، موسوم به «شهر اینکا»(Inca) قرار دارند، شناسایی شدند.
به نقل از لاگرادا، این ساختارها که وسعتی بین ۴۵ متر تا ۱ کیلومتر دارند، در طول بهار مریخی و زمانی که لایههای یخ کربن دیاکسید شروع به ذوب شدن میکنند یا در مورد لایههای زیرین، تصعید میشوند و مستقیماً از جامد به گاز تبدیل میشوند، شکل میگیرند. گاز، منبسط شده و بالا میرود و با انفجار از لایههای یخ خارج میشود. این امر باعث ایجاد فوارههای غبار تیره از سطح میشود و آن نقشی را که شبیه به عنکبوت است، خلق میکند.
فرضیه تشکیل «شهر اینکا» یا «Angustus Labyrinthus» توسط تپههای ماسهای در سال ۲۰۰۲، زمانی که مدارگرد مریخ نشان داد این منطقه یک طرح دایرهای به قطر ۸۶ کیلومتر است، رد شد. دانشمندان معتقدند که این ساختار نتیجه یک دهانه برخوردی، یعنی حاصل یک برخورد با سیاره است.
شهر اینکا
این منطقه یک ساختار سطحشناختی در سیاره مریخ است که در نزدیکی قطب جنوب آن قرار دارد و در سال ۱۹۷۲ توسط فضاپیمای «مارینر ۹»(Mariner ۹) ناسا کشف شد. تصاویر دریافت شده در نگاه اول شبیه به خرابههای باستانی با پشتهها و درههای به هم پیوسته به نظر میرسیدند. این مشاهدات با وجود نام خود، یک تمدن احتمالی نیست، بلکه ساختارهایی است که در نتیجه فرآیندهای سطحشناختی مانند برخورد یک سیارک ایجاد شدهاند.
دانشمندان بر این باورند که این برخورد باعث ترک خوردن پوسته مریخ شده و به ماگما اجازه داده تا بالا بیاید و این دیوارهها را تشکیل دهد. فرسایش در طول زمان کار تاثیر خود را گذاشته و مواد نرمتر و دیوارههای سنگی سخت را آشکار کرده است که به آن ظاهری شبیه به یک شهر میدهد، با این وجود، این یک شهر واقعی نیست.
عنکبوتهای مریخی
با فرا رسیدن بهار مریخی در نیمکره جنوبی این سیاره، دما شروع به افزایش میکند و باعث ذوب شدن لایههای یخ کربن دیاکسید میشود. این امر باعث میشود که لایههای پایینتر یخ تصعید شده و به گاز تبدیل شوند. این گاز پس از انبساط و بالا آمدن به سطح، همراه با غبار سطحی، فوارههای غبار ایجاد میکند که مسئول این الگوهای عنکبوتمانند هستند. ما در مورد آبفشانهایی صحبت میکنیم که طبق گفته «آژانس فضایی اروپا»، میتوانند یخهایی به ضخامت ۱ متر را بشکنند.
همانطور که اشاره کردیم، تصاویری که ابتدا از «شهر اینکا» به دست آمد، دانشمندان را به این فکر انداخت که پشتههای خطی که شبیه خرابهها به نظر میرسیدند، ممکن است تپههای ماسهای سنگشده یا بقایای یخچالهای مریخی باشند. به لطف مدارگرد مریخ در سال ۲۰۰۲، تصاویر واضحی به دست آمد که نشان داد نظریههای موجود بسیار دور از واقعیت هستند.
دانشمندان اکنون معتقدند که این موضوع نتیجه یک برخورد با سیاره بوده که به این دهانه برخوردی باستانی منجر شده است. این نظریه نشان میدهد که این پشتههای هندسی ناشی از نفوذ ماگما هستند که پس از برخورد، از طریق پوسته ترک خورده بالا آمده است. طبق این نظریه، دهانه با رسوباتی پر شده که فرسایش یافتهاند و به این شکلهای قابل مشاهده که از نظر چشم انسان شبیه به خرابههای باستانی هستند، منجر شده است.
انتهای پیام
